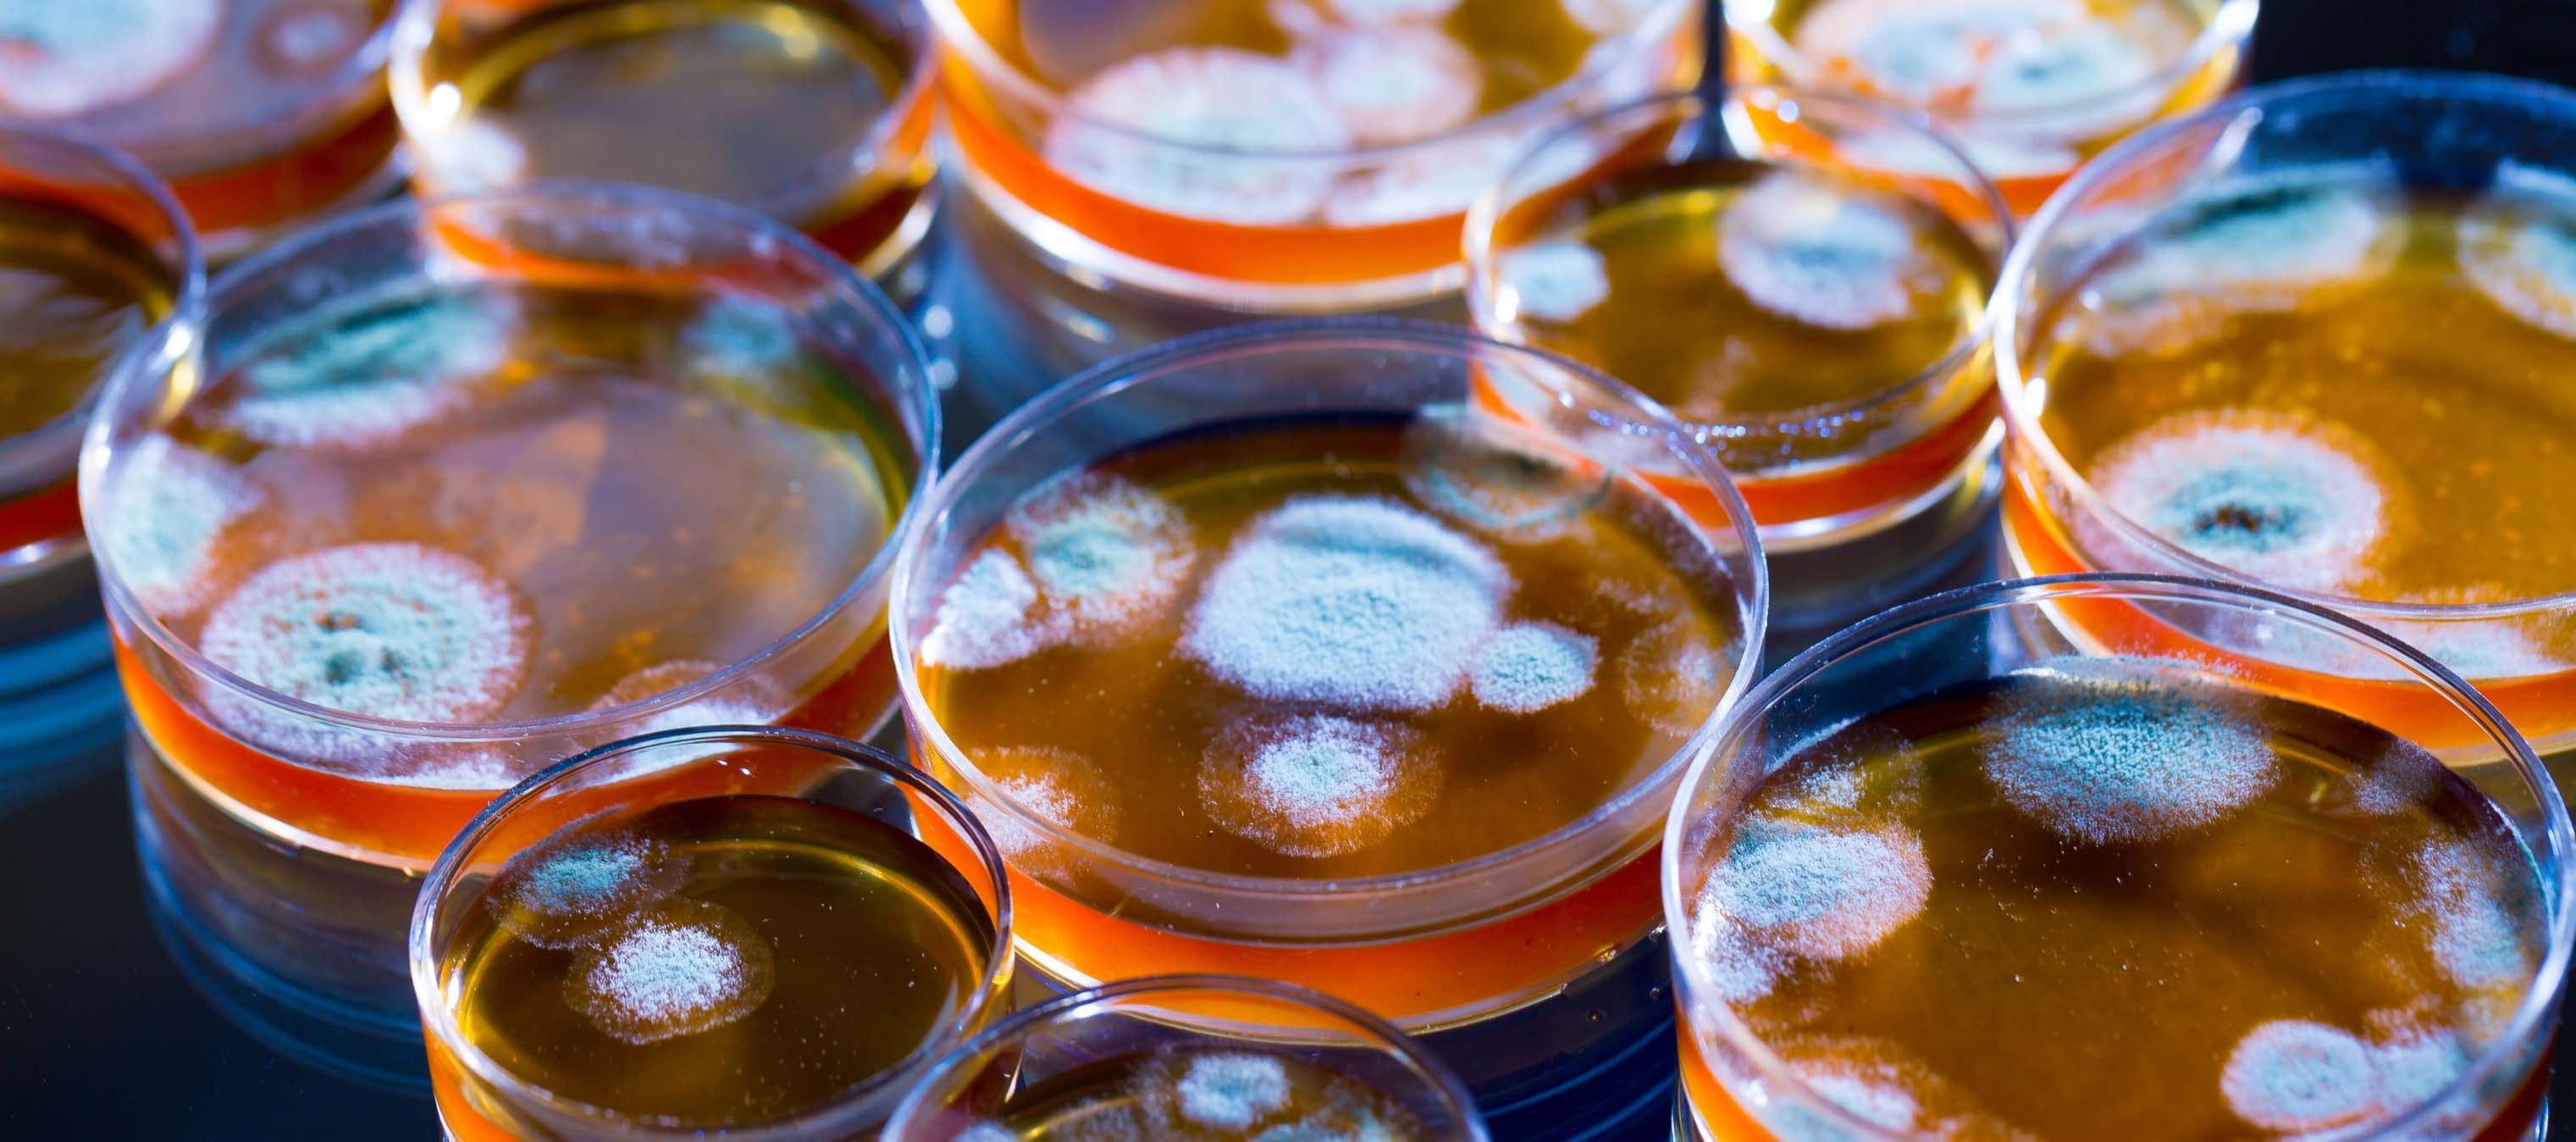
Penicilina

Cuando pensamos en la innovación en tiempos de guerra, solemos imaginar avances espectaculares: el descifrado del código nazi Enigma por parte de Alan Turing, la invención del radar, el desarrollo de la bomba atómica en el Proyecto Manhattan. Pero una innovación biológica menos visible —la producción masiva de penicilina— fue igual de transformadora.
Aunque Alexander Fleming identificó las propiedades antibacterianas de la penicilina en 1928, esta siguió siendo frágil, inestable y casi imposible de producir en cantidades significativas durante más de diez años. Fue recién en la Segunda Guerra Mundial que la penicilina se convirtió en un tratamiento que pudo producirse, distribuirse y utilizarse ampliamente.
Lo que estaba en juego no podía ser más importante. Las estimaciones de registros militares indican que, durante la Primera Guerra Mundial, entre el 12% y el 15% de los soldados heridos en combate murieron a causa de infecciones bacterianas. En algunas lesiones —especialmente las fracturas de fémur—, la tasa de mortalidad alcanzó el 80%, casi exclusivamente debido a complicaciones posteriores a la herida. La supervivencia muchas veces dependía menos de la lesión que de la pura suerte.
En los últimos años de la Segunda Guerra Mundial, una vez que los aliados comenzaron a producir penicilina en masa, los resultados médicos cambiaron drásticamente. Los registros militares muestran tasas de recuperación de infecciones cercanas al 95%, superando con creces la eficacia de los antisépticos y las sulfamidas anteriores. La mortalidad por infecciones por heridas comparables se redujo a aproximadamente un 3-4%, y se estima que la penicilina evitó decenas de miles de amputaciones que antes habrían sido necesarias para detener la propagación de la gangrena. Igual de importante es que redujo drásticamente los tiempos de recuperación, acortando la convalecencia de meses a solo unas pocas semanas.
La producción masiva de penicilina fue tan crucial para el esfuerzo bélico aliado como cualquier avance en criptografía o física nuclear. A pesar de su formidable capacidad científica, Alemania no lo logró. Las investigaciones comenzaron tarde, se limitaron a un puñado de laboratorios universitarios y se estancaron en la fase experimental, ya que los científicos nazis carecían de acceso a cepas de alto rendimiento, métodos avanzados de fermentación y, más esencial, la coordinación institucional necesaria para la producción a gran escala.
La experiencia de los aliados fue marcadamente diferente. A partir de 1941, Estados Unidos movilizó su infraestructura científica e industrial a través de la Oficina de Investigación y Desarrollo Científico de Vannevar Bush, financiando proyectos de investigación paralelos en universidades, laboratorios públicos y empresas privadas, al mismo tiempo que asumía los riesgos financieros y científicos. Al adaptar las técnicas de fermentación en tanques profundos —desarrolladas originalmente para el procesamiento de alimentos y la química industrial—, 21 empresas estadounidenses, entre ellas Pfizer, pudieron producir millones de dosis de penicilina a tiempo para el Día D.
Tres características del sistema de innovación estadounidense resultaron decisivas. En primer lugar, la fabricación de penicilina solo pudo ampliarse gracias a la inversión sostenida en tecnologías civiles desarrolladas mucho antes de la guerra, como la fermentación, la microbiología y la ingeniería industrial. Esta base tecnológica no militar se convirtió en un activo estratégico en tiempos de guerra. Alemania, a pesar de su fortaleza en química sintética, carecía del ecosistema industrial diversificado necesario para fabricar antibióticos a gran escala.
En segundo lugar, el entorno de innovación de Estados Unidos estuvo moldeado por un gobierno dispuesto a asumir riesgos. Al comienzo de la guerra, la penicilina era experimental, cara y muy incierta, lo que les daba a las empresas privadas pocos incentivos para invertir. Pero la administración del presidente Franklin Roosevelt reconoció que el progreso tecnológico requiere tolerancia al fracaso. A través de la Oficina de Investigación y Desarrollo Científico, financió una amplia gama de iniciativas exploratorias, pensando que muchas de ellas fracasarían. Al hacerlo, permitió que surgieran y se ampliaran los enfoques más prometedores. El sistema de investigación más centralizado de Alemania, en cambio, priorizaba la rentabilidad militar inmediata y desalentaba la experimentación indefinida.
En tercer lugar, Estados Unidos construyó un sistema de innovación que, aunque disperso, estaba sumamente integrado y vinculaba la inversión pública, los descubrimientos académicos y la ejecución industrial. El gobierno estableció las prioridades y asumió los riesgos iniciales; las universidades y los laboratorios impulsaron la ciencia; y las empresas privadas trasladaron los descubrimientos a la producción en masa. Esta división del trabajo les proporcionó a los aliados una ventaja tecnológica que la Alemania nazi, limitada por la rigidez institucional, no pudo replicar.
En un artículo reciente, junto con mis coautores argumentamos que la historia de la penicilina ilustra un patrón más amplio en la evolución de la tecnología estadounidense. Desde la Segunda Guerra Mundial, los avances más transformadores liderados por Estados Unidos —desde los semiconductores hasta la biotecnología— se han basado en un marco institucional distintivo: investigación básica financiada con fondos públicos, universidades e instituciones de investigación sólidas, un sector privado competitivo capaz de escalar las nuevas tecnologías y grandes beneficios sociales derivados de la inversión pública en salud y educación.
La penicilina, inicialmente justificada como una inversión en defensa, acabó teniendo un impacto tan grande en la guerra como cualquier arma, y transformó la medicina civil y la salud global. En este sentido, el activo más poderoso de Estados Unidos en tiempos de guerra no fue una tecnología concreta, sino el sistema que hizo posibles esos avances.
Los relatos de la victoria de los aliados suelen destacar un conjunto reducido de logros tecnológicos. En realidad, los aliados prevalecieron no solo porque construyeron mejores armas, sino porque crearon un ecosistema de innovación más profundo y adaptable, lo suficientemente flexible como para convertir el conocimiento científico en herramientas prácticas que salvaban vidas cuando más importaba.
Ese sistema no surgió por casualidad. Fue el resultado de decisiones políticas deliberadas que alinearon la investigación académica, la capacidad industrial y el desarrollo institucional —un nexo que la administración de Donald Trump está poniendo en peligro al recortar la financiación de la investigación básica y la inversión específica, especialmente en salud (NIH) y ciencia (NSF)—. Los responsables de las políticas de hoy deben recordar la lección del desarrollo de la penicilina en tiempos de guerra: la verdadera seguridad depende tanto del fomento de la innovación como del armamento.
---
Paolo Surico es profesor de Economía en la London Business School.